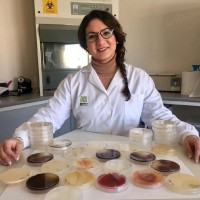
Beatriz Sánchez Arcas

Crop Production
Oilseed and Grain Farming
Vegetable and Melon Farming
Fruit and Tree Nut Farming
Greenhouse, Nursery, and Floriculture Production
Other Crop Farming
Soybean Farming
Oilseed (except Soybean) Farming
Dry Pea and Bean Farming
Wheat Farming
Corn Farming
Rice Farming
Other Grain Farming
Orange Groves
Citrus (except Orange) Groves
Noncitrus Fruit and Tree Nut Farming
Food Crops Grown Under Cover
Nursery and Floriculture Production
Tobacco Farming
Cotton Farming
Sugarcane Farming
Hay Farming
All Other Crop Farming
Oilseed and Grain Combination Farming
All Other Grain Farming
Potato Farming
Other Vegetable (except Potato) and Melon Farming
Apple Orchards
Grape Vineyards
Strawberry Farming
Berry (except Strawberry) Farming
Tree Nut Farming
Fruit and Tree Nut Combination Farming
Other Noncitrus Fruit Farming
Mushroom Production
Other Food Crops Grown Under Cover
Nursery and Tree Production
Floriculture Production
Sugar Beet Farming
Peanut Farming
All Other Miscellaneous Crop Farming